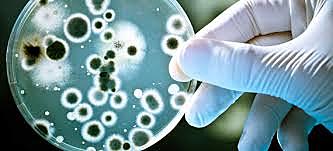
BATALLA CON BACTERIAS

-
Sacan a relucir los fundamentos de respeto a la vida y sobretodo de la atención a los necesitados.
-
Inyecta a 22 obreros inmigrantes hispánicos con el agente de la fiebre amarilla, pagándoles $100 si sobrevivían y $200 si contraían la enfermedad
-
Un médico en Mississippi, quien trabajaba en la Oficina de Salud Pública de los Estados Unidos produjo PELAGRA en doce internos en el intento de descubrir una cura para esta enfermedad
-
-
Carrie Buck of Charlottesville es legalmente esterilizada contra su voluntad en el Hogar Virginia Colony para enfermos mentales. Carrie Buck era la hija mentalmente sana de una madre con retardo mental, pero bajo la ley de Virginia ella fue declarada como una potencial procreadora de un hijo subnormal.
-
17 estados de los USA tenían leyes que permitían la esterilización forzosa. La sentencia de Poe vs.
-
Alemania: ley de respeto a la autonomía exige Consentimiento Informado (CI)/investigación de los medicamentos como experimentación con humanos
-
En Alemania mueren 75 niños en el experimento pediátrico con la vacuna para la tuberculosis
-
USA permite experimentación con seres humanos con CI
-
Punto de congelamiento: Experimentación en el cuerpo humano (Dr Sigmund Rascher)
Agua de mar: Se experimentaba con militares desalinización agua de mar.
Enfermedades:convulsiones, alusinaciones y locura. (Dr Wilhelm Beiglboeck)
Traumatología: Injertos óseos y nerviosos experimentos más brutales e inhumanos. (Herta Oberhauser)
Gemelos: 1500 pares de gemelos para su estudio y experimentación. (Dr Joseph Mengele) -
Efectos del gas mostaza para el tratamiento de las heridas.
-
22 niños que vivían en el Orfanato de los Soldados de Lowa en Davenport fueron los sujetos del ‘’Monster experiment’’ que utilizo presión psicológica para inducir a los niños a que tenían un habla normal a que se convirtieran en tartamudos.
El experimento fue diseñado por uno de los más famosos terapeutas de lenguaje, el Dr. Wendell Johnson, con el fin de poner a prueba su teoría acerca de la tartamudez. -
En un programa de choque para desarrollar nuevos medicamentos para ‘’combatir’’ la malaria durante la Segunda Guerra Mundial, médicos en Chicago infectaron cerca de 400 prisioneros con la enfermedad.
A pesar de que a los internos de Chicago se les proporcionó información general respecto a que estaban colaborando con los objetivos de la guerra de Alemania, no fueron informados acerca de la naturaleza del experimento -
Experimentos para investigar la efectivad de la sulfamida e infección a los sujetos de batalla con bacterias.
-
Experimentos de regeneración y trasplantes de hueso realizados en mujeres prisioneras en el campo de concentración de Ravensbrück.
-
Experimentos de congelamiento conducido con enfermos mentales en cabinas de refrigeración a temperaturas de 30 grados durante 120 horas, en el Hospital Universitario de Cincinatti, con el fin de estudiar los efectos de estas bajas temperaturas en los desórdenes mentales.
-
Experimentación de Buchenwald para evaluar efectos de varias preparaciones farmacéuticas en las quemaduras con fósforo.
-
-
La Asamblea General, creada en virtud de la Carta de las Naciones Unidas, ocupa un lugar central, ya que es el órgano principal de las Naciones Unidas de deliberación, adopción de políticas y representación. También desempeña una función importante en el proceso de establecimiento de normas y en la codificación del derecho internacional.
-
-
Juicios de Nuremberg, 24 médicos fueron procesados por los delitos cometidos en el Holocausto.
-
El trato secreto de los Estados Unidos con Ishii y los líderes de la Unidad 731 descubrió los datos de gérmenes utilizados en la guerra basados en experimentación humana a cambio de inmunidad para la prosecución de crímenes de guerra.
-
La Atomic Energy Commission apoyó estudios conducidos en la Fernald School in Massachusetts. Los residentes fueron alimentados con Avena Quaker en el cereal del desayuno conteniendo trazas radioactivas.
-
“Juicio de los doctores”.Médicos fueron procesados en USA por delitos cometidos.
-
Consejo de crímenes de guerra definen invstigación médica legítima, por lo que constituyen el código de Nuremberg. (Dr Leo Alexander)
A raíz de esto nace el código de Nuremberg, que rige la obligación de cumplir con CI, y se basa en los principios eticos, morales y legales. -
Fue publicado en esta fecha, como producto del Juicio de Núremberg junto con la jerarquía nazi,en la cual resultaron condenados varios médicos por graves atropellos a los derechos humanos. Es el primer documento que planteó explícitamente la obligación de solicitar el Consentimiento Informado y la expresión de la autonomía del paciente.
-
La Asociación Médica Mundial (AMM) es una organización internacional que representa a los médicos. Fue fundada cuando médicos de 27 países diferentes se reunieron en la Primera Asamblea General de la AMM, en París. La organización fue creada para asegurar la independencia de los médicos y para servir los niveles más altos posibles en conducta ética y atención médica, en todo momento.
-
-
Niños enfermos mentales de la Escuela de WILLOWBROOK (Nueva York) fueron infectados deliberadamente con hepatitis en un intento por encontrar la vacuna. La participación en el estudio fue la condición para ser admitido en la institución
-
Dr. Albert Sabin pone a prueba experimental la vacuna de polio en 133 prisioneros de Ohio.
-
El auténtico precedente de la Declaración es el documento titulado «Principles for those in Research and Experimentation» aprobado por la 8.ª Asamblea General en Roma en el año 1954.
Después hubo un borrador en 1962 y, urgidos por diversas denuncias de experimentos no éticos, se adoptó el documento definitivo en 1964 en la 18.ª Asamblea General celebrada en Helsinki. -
Fundaba los postulados éticos en la integridad moral y responsabilidad del médico.
-
-
Henry Beecher, profesor de Anestesia en Harvard, publicaba en el New England Journal of Medicine, un artículo en el que describía 22 experimentos en seres humanos en los que no se respetaron normas éticas básicas, como la del consentimiento informado de los sujetos de investigación
-
-
Es en estos años cuando comienza a proponerse la necesidad de la revisión por comités independientes, algo que la primera Declaración ni siquiera atisbó
-
Promulga en 1966 unas directrices exigiendo el consentimiento y la revisión externa, directrices que se revisarían en 1969 y 1971.
-
Elaborada por la Asociación Americana de Hospitales, presenta estos derechos para que sean respaldados por el hospital en nombre de sus pacientes, como parte integral del proceso de sanar.
-
La autorregulación de los médicos a que aspiraba la Declaración se da por fracasada y la investigación biomédica con seres humanos entra en una nueva dimensión: el control público.
-
En el mismo año se crea la National Comission for the Protection of Human Subjects of Biomedical and Behavioral Research
-
La Declaración de Helsinki se elaboró para evitar que el control ético de la investigación saliera del ámbito de la profesión médica. No lo consiguió. Pero a partir de su segunda revisión en Tokio (1975), en la que se incluyeron cambios notables, como la valoración por comités independientes, se convirtió en una referencia ética en la práctica, a medida que fue incorporada a las legislaciones nacionales.
-
-
Principios y guías éticos para la protección de los sujetos humanos de investigación biomédica y del comportamiento.
-
El Departamento de Salud, Educación y Bienestar de los EEUU. “Principios éticos y pautas para la protección de los seres humanos en la investigación”. Impulsado por el Estudio Tuskegee. Tres principios éticos básicos para la investigación en humanos:
Autonomía (respeto por las personas)
Beneficencia
Justicia -
-
Publicó el documento “Propuesta de Pautas Internacionales para la Investigación Biomédica en Seres Humanos”.
El objetivo era indicar cómo podrían aplicarse eficazmente los principios éticos fundamentales que guían la investigación biomédica en seres humanos, tal como se establece en la Declaración de Helsinki de la Asociación Médica Mundial. -
-
Por la cual se organiza el Sistema Nacional de Salud y se dictan otras disposiciones, determina que corresponde al Ministerio de Salud formular las políticas y dictar todas las normas científico- administrativas, de obligatorio cumplimiento por las entidades que integran el Sistema,
-
Por el cual se reestructura el Ministerio de Salud y se determinan las funciones de sus dependencias, establece que éste formulará
las normas científicas y administrativas pertinentes que orienten los recursos y acciones del Sistema. -
-
-
• Se establecen los requisitos para el desarrollo de la actividad investigativa en salud.
• La Investigación en humanos, deberá tener un Comité de Ética en Investigación, encargado de resolver todos los asuntos relacionados con el tema. -
• Estudio de las comunidades debe ser voluntaria y que tenga un beneficio razonable
• las investigaciones en comunidades solo se pueden hacer por entidades que tengan comité de ética -
• Las investigaciones en menores de edad deben asegurar que previamente se hayan hecho estudios semejantes en personas mayores de edad y en animales inmaduros; excepto cuando se trate de estudios de condiciones que son propias de la etapa neonatal o padecimientos específicos de ciertas edades.
-
• En las investigaciones clasificadas como de riesgo mayor que el mínimo, Las mujeres deben certificar que no están embarazadas .
• Para realizar investigaciones en mujeres en embarazo se debe solicitar el consentimiento informado. -
- Estudiantes, empleados, reclusos, miembros de fuerzas militares etc.
- Para realizar investigaciones en estos grupos se debe garantizar la participación en el Comité de Ética en Investigación, de uno o más miembros de la población de estudio, capaz de representar los valores morales, culturales y sociales del grupo en cuestión y vigila
-
ART 46. Participación de uno o más miembros del grupo subordinado a estudio en el Comité de Ética en Investigación.
-
ART 48. Debido respeto al cadáver humano.
-
CAPITULO I.
DISPOSICIONES GENERALES.
ART 49. Investigación en seres humanos, sobre nuevos recursos profilácticos, de diagnóstico, terapéuticos y de rehabilitación. -
Investigación farmacológica; actividades científicas tendientes al estudio de medicamentos y productos biológicos para uso humano.
-
ART 60. Actividades científicas tendientes al estudio de materiales, injertos, trasplantes, prótesis, procedimientos físicos, químicos y quirúrgicos, instrumentos, aparatos, órganos artificiales y otros.
-
-
ART 63. Investigadoras en las que se realice investigación con microorganismos patógenos o material biológico.
-
ART 73. Se entenderá por ácidos nucleicos recombinantes a las nuevas combinaciones de material genético obtenidas fuera de una célula viviente.
-
ART 78. Cumplimiento de los requisitos y obligaciones, como encargado de la seguridad radiológica.
-
ART 87. Ley 84 de 1989, tener en cuenta.
-
48ª Asamblea General Somerset West, Sudáfrica, octubre 1996. Documento Internacional para la regulación de la investigación en ser humano.
-
Documento Internacional para la regulación de la investigación en ser humano; basado en principios éticos que orientan al medico y demás profesionales que realizan investigaciones medicas en seres humanos.
- Principios básicos
- Grupos y personas vulnerables
- Comité de ética
- privacidad y confidencialidad
- Principios aplicables en combinación de investigación y atención medica
-
-
-
52ª Asamblea General Edimburgo, Escocia, octubre 2000.
Documento Internacional para investigaciones en seres humanos que propone principios éticos para orientar a los médicos y demás profesionales en dichas investigaciones.- Principios básicos
- Grupos y personas vulnerables
- Comité de ética
- privacidad y confidencialidad
- Principios aplicables en combinación de investigación y atención medica
-
-
-
-
Dig. humana y derechos humanos
Beneficios y efectos nocivos
Autonomía y resp. individual
Consentimiento
Resp. de la vulnerabilidad humana y la inte personal
Privacidad y confidencialidad
Igualdad, justicia y equidad
No discriminación y no estigmatización
Respt de la diversidad cultural y del pluralismo
Solidaridad y coop.
Respon. social y salud
Protección de las generaciones futuras
Protección del medio amb., la biosfera y la biodiversidad
Adopción de decisiones y tto de las cuestiones bioéticas
Want to make a timeline like this?
Use Timetoast to turn dates, events, milestones, and phases into a clear visual timeline you can build and share. Timetoast is a timeline maker for work, school, research, and stories.